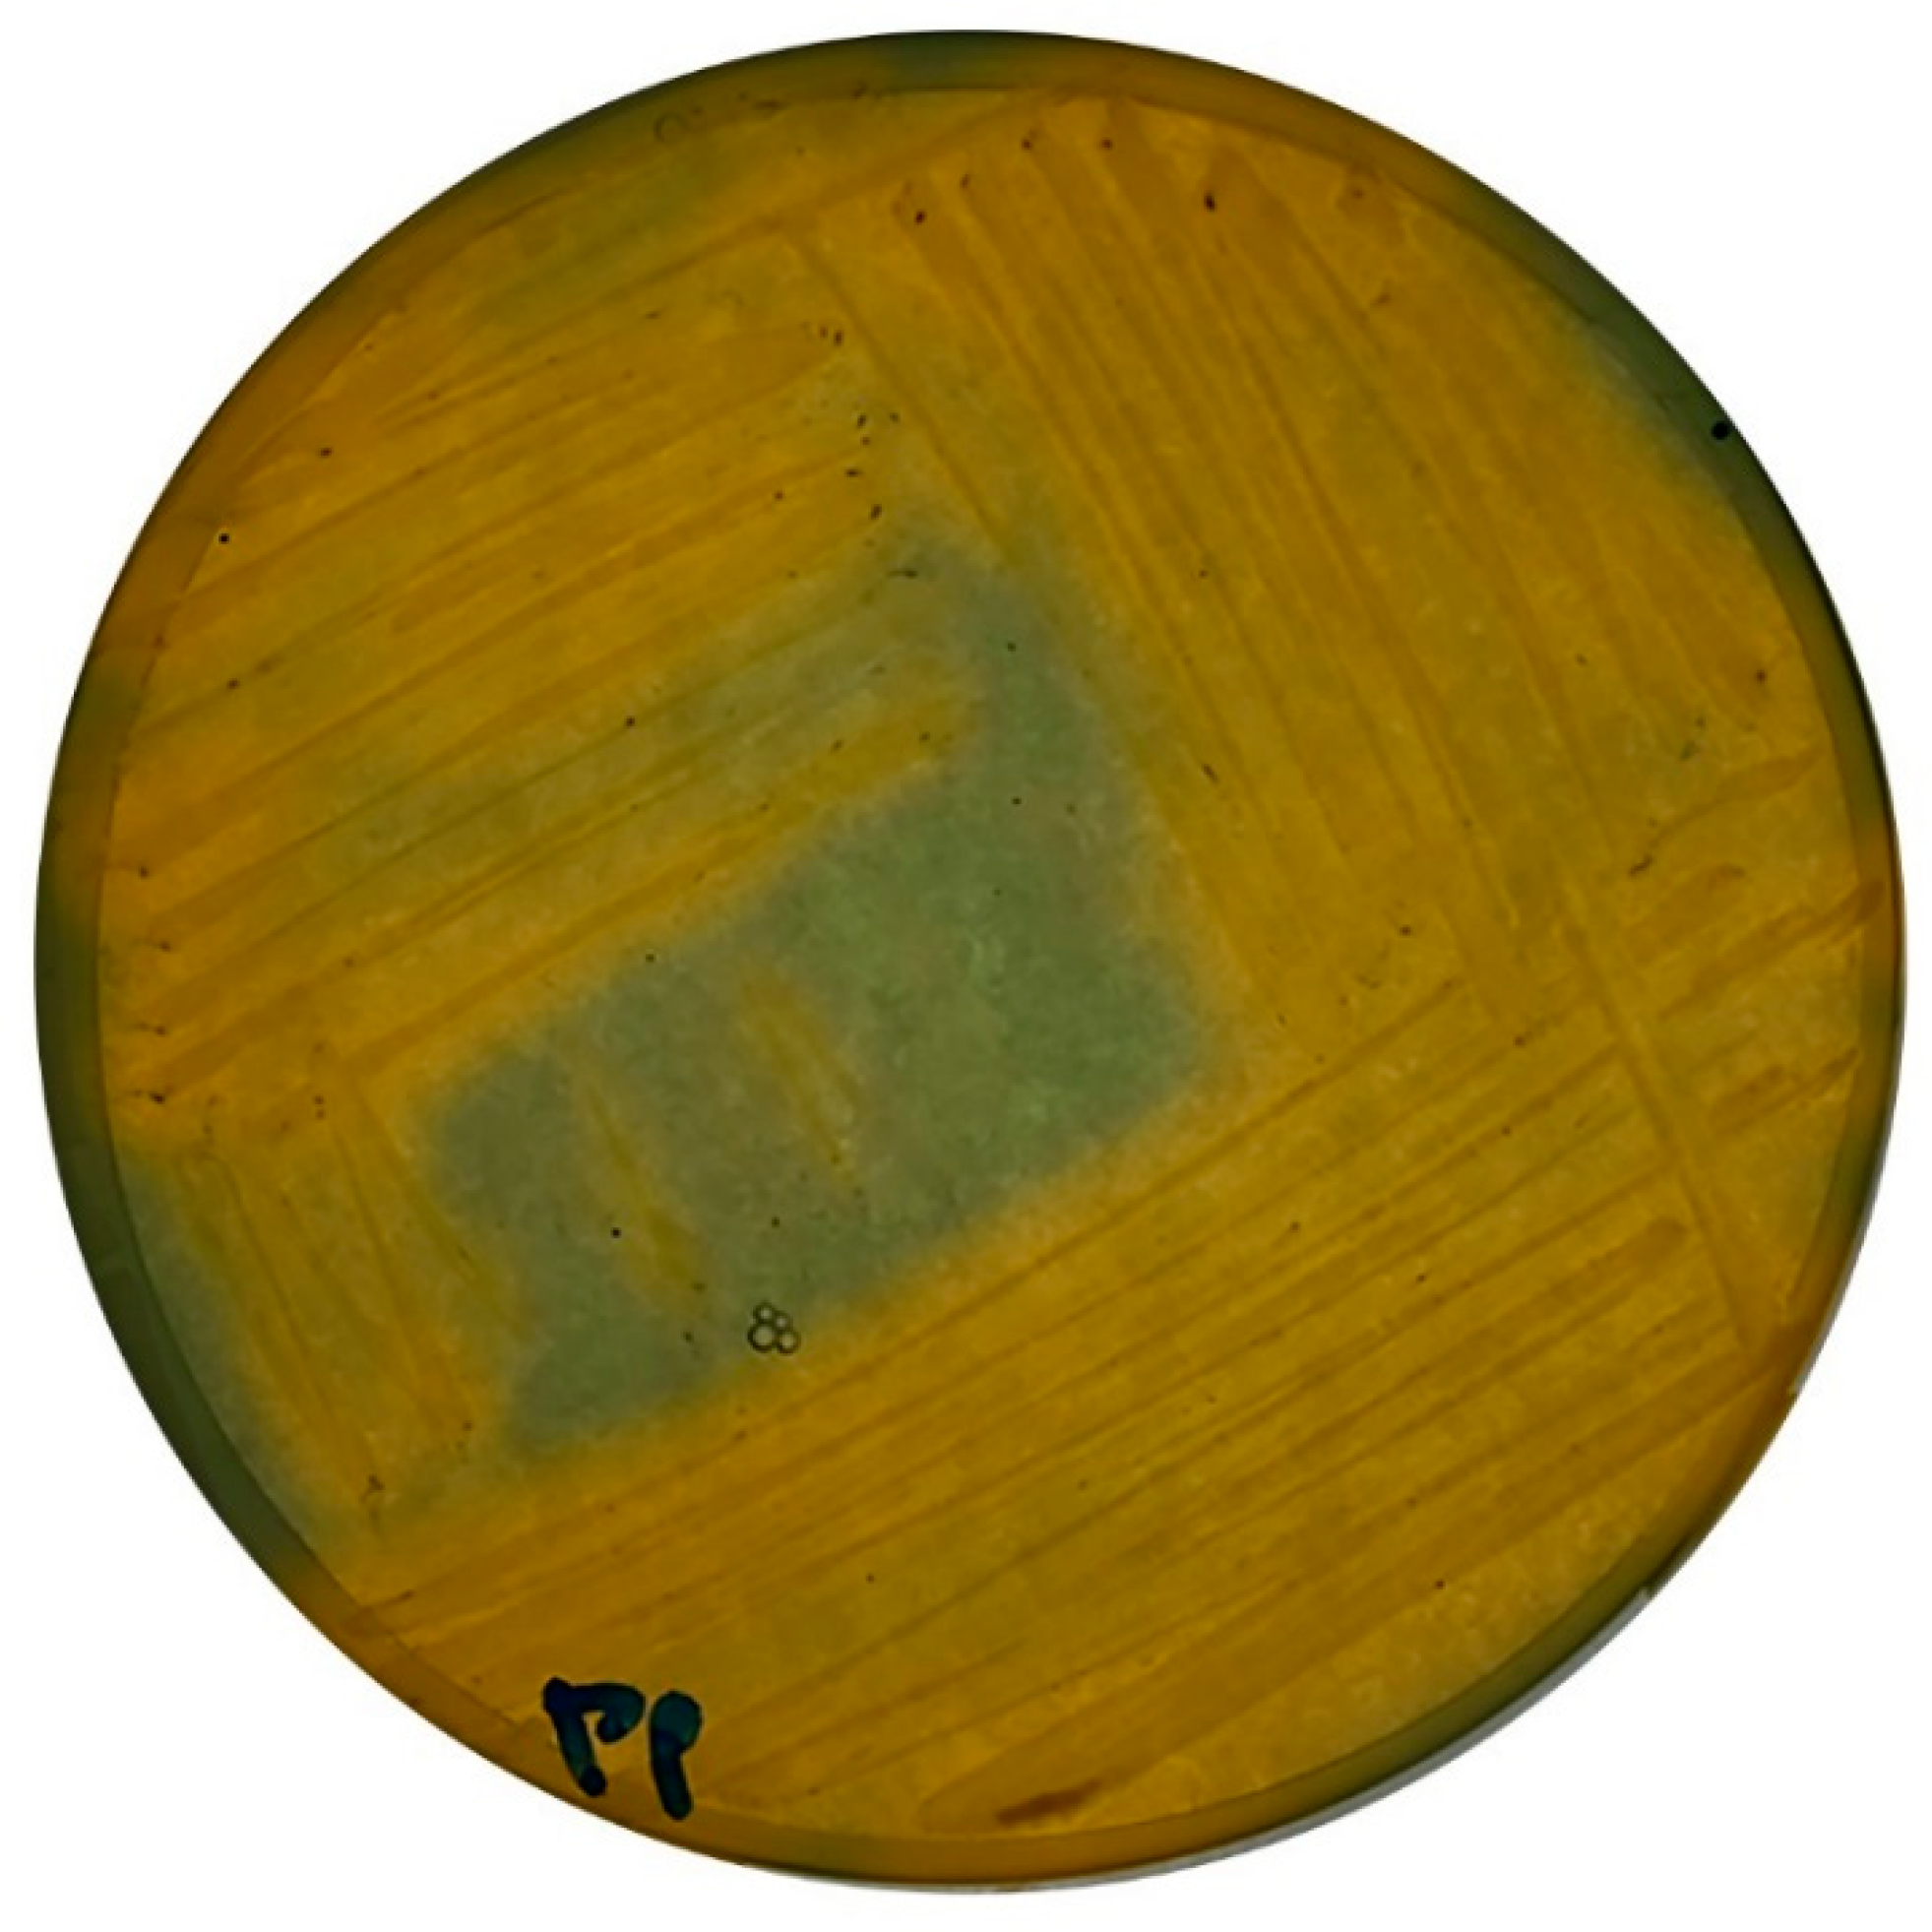
Cmd 02 00015 g004

Microbial-Driven Stabilisation of Archaeological Iron Artefacts
Abstract
:1. Introduction
2. Materials and Methods
2.1. Bacterial Cultivation
2.2. Iron Source
2.3. Salt Influence on Bacterial Growth
2.4. Agitation Effect on Biomineralisation
2.5. Application of Oxygen Scavengers on Biomineralisation
2.6. Characterisation and Assessment
2.6.1. SpectraMax i3x Multi-Mode
2.6.2. Vis Spectrophotometer (VSP)
2.6.3. pH Test
2.6.4. Drying and Preparation Protocol
2.6.5. Inductive Coupled Plasma-Optical Emission Spectroscopy (ICP-OES)
2.6.6. Scanning Electron Microscopy Coupled with Energy Dispersive X-Ray Spectroscopy (SEM-EDS)
2.6.7. X-ray Diffraction (XRD)
3. Results and Discussion
3.1. Salt Parameters
3.2. Agitation Versus Static
3.3. Oxygen Scavengers
4. Conclusions
Supplementary Materials
Author Contributions
Funding
Institutional Review Board Statement
Informed Consent Statement
Data Availability Statement
Acknowledgments
Conflicts of Interest
References
- Bottrill, M.C.; Pressey, R.L. The effectiveness and evaluation of conservation planning. Conserv. Lett. 2012, 5, 407–420. [Google Scholar] [CrossRef]
- Dietze-Uldry, S.; (Service Archéologique du Canton de Bern, Suisse); Küpfer, L.; (Laboratoire MCAH, Lausanne, Switzerland). Personal communication, 2020.
- Réguer, S.; Neff, D.; Remazeilles, C.; Guilminot, E.; Nicot, F.; Pelé, C.; Meguelati, M.; Mirambet, F.; Dillmann, P.; Refait, P.; et al. Desalinisation of iron archaeological artefacts: Understanding of chlorine removal mechanisms of the corrosion layers with the help of characterisation techniques. In Metal 07: Interim Meeting of the ICOM-CC Metal WG Amsterdam, 17–21 September 2007; Rijksmuseum: Amsterdam, The Netherlands, 2007; pp. 60–68. [Google Scholar]
- Gerwin, W.; Baumhauer, R. Effect of soil parameters on the corrosion of archaeological metal finds. Geoderma 2000, 96, 63–80. [Google Scholar] [CrossRef]
- Ståhl, K.; Nielsen, K.; Jiang, J.; Lebech, B.; Hanson, J.C.; Norby, P.; van Lanschot, J. On the akaganéite crystal structure, phase transformations and possible role in post-excavational corrosion of iron artifacts. Corros. Sci. 2003, 45, 2563–2575. [Google Scholar] [CrossRef]
- Keller, P. Eigenschaften von (C1,F,OH) < 2Fe8(O,OH)16 und akaganéit. Neues Jahrb. Min. 1970, 113, 29–49. [Google Scholar]
- Reguer, S.; Mirambet, F.; Bellot-Gurlet, L.; Dillmann, P. Local and structural characterisation of chlorinated phases formed on ferrous archaeological artefacts by mu XRD and mu XANES. Nucl. Instrum. Methods Phys. 2005, 240, 500–504. [Google Scholar] [CrossRef]
- Watkinson, D. Measuring effectiveness of washing methods for corrosion control of archaeological iron: Problems and challenges. Corros. Eng. 2010, 45, 400–406. [Google Scholar] [CrossRef] [Green Version]
- Watkinson, D.E.; Emmerson, N.J. The impact of aqueous washing on the ability of βFeOOH to corrode iron. Environ. Sci. Pollut. Res. 2016, 24, 2138–2149. [Google Scholar] [CrossRef] [Green Version]
- Bland, P.A.; Kelley, S.P.; Berry, F.J.; Cadogan, J.M.; Pillinger, C.T. Artificial weathering of the ordinary chondrite Allegan; implications for the presence of Cl-as a structural component in akaganeite. Am. Miner. 1997, 82, 1187–1197. [Google Scholar] [CrossRef]
- Watkinson, D.; Lewis, M.T. Desiccated storage of chloride-contaminated archaeological iron objects. Stud. Conserv. 2005, 50, 241–252. [Google Scholar] [CrossRef]
- Rimmer, M.; Thickett, D.; Watkinson, D.; Ganiaris, H. Guidelines for the Storage and Display of Archaeological Metalwork; English Heritage: Swindon, UK, 2013. [Google Scholar]
- Zucci, F.; Morigi, G.; Bertolasi, V. Beta iron oxide hydroxide formation in localized active corrosion of iron artifacts. Corrosion and metal artifacts: A dialogue between conservators and archaeologists. Natl. Bur. Stand. Spec. Publ. 1977, 479, 103–106. [Google Scholar]
- Selwyn, L.S.; Sirois, P.J.; Argyropoulos, V. The corrosion of excavated archaeological iron with details on weeping and akaganéite. Stud. Conserv. 1999, 44, 217. [Google Scholar] [CrossRef]
- Watkinson, D. Degree of mineralisation: Its significance for the stability and treatment of excavated ironwork. Stud. Conserv. 1983, 28, 85–90. [Google Scholar]
- Thickett, D. Post Excavation Changes and Preventive Conservation of Archaeological Iron. Ph.D. Thesis, University of London, London, UK, 2012. Available online: https://production.english-heritage.org.uk/siteassets/home/learn/conservation/collections-advice--guidance/thickettthesisfinalversion.pdf (accessed on 5 June 2020).
- Logan, J. Care and Cleaning of Iron; CCI Notes; Minister of Public Works and Government Services Canada: Quebec, QC, Canada, 2007; pp. 1–4.
- Walker, R. Instability of iron sulfides on recently excavated artifacts. Stud. Conserv. 2001, 46, 141–152. [Google Scholar]
- Rémazeilles, C.; Saheb, M.; Neff, D.; Guilminot, E.; Tran, K.; Bourdoiseau, J.-A.; Sabot, R.; Jeannin, M.; Matthiesen, H.; Dillmann, P.; et al. Microbiologically influenced corrosion of archaeological artefacts: Characterisation of iron (II) sulfides by Raman spectroscopy. J. Raman Spectrosc. 2010, 41, 1425–1433. [Google Scholar] [CrossRef]
- Neff, D.; Reguer, S.; Bellot-Gurlet, L.; Dillmann, P.; Beranger, G. Corrosion of iron archaeological artefacts in soil: Characteri-sation of the corrosion system. Corros. Sci. 2005, 47, 515–535. [Google Scholar] [CrossRef]
- Rimmer, M.; Watkinson, D.; Wang, Q. The impact of chloride desalination on the corrosion rate of archaeological iron. Stud. Conserv. 2013, 58, 326–337. [Google Scholar] [CrossRef]
- Rimmer, M. Investigating the Treatment of Chloride-Infested Archaeological Iron Objects. Ph.D. Thesis, Cardiff University, Cardiff, UK, 2010. [Google Scholar]
- Rimmer, M.; Wang, Q. Assessing the effects of alkaline desalination treatments for archaeological iron using Scanning electron microscopy. Br. Mus. Tech. Res. Bull. 2010, 4, 79–86. [Google Scholar]
- Näsänen, L.M.; González-Pereyra, N.G.; Cretté, S.A.; DeViviés, P. The applicability of subcritical fluids to the conservation of actively corroding iron artifacts of cultural significance. J. Supercrit. Fluids 2013, 79, 289–298. [Google Scholar] [CrossRef]
- Zou, X.; Gu, S.; Lu, X.; Xie, X.; Lu, C.; Zhou, Z.; Ding, W. Electroreduction of iron (III) oxide pellets to iron in alkaline media: A typical shrinking-core reaction process. Met. Mater. Trans. A 2015, 46, 1262–1274. [Google Scholar] [CrossRef] [Green Version]
- Watkinson, D.E.; Rimmer, M.B.; Emmerson, N.J. The influence of relative humidity and intrinsic chloride on post-excavation corrosion rates of archaeological wrought iron. Stud. Conserv. 2019, 64, 456–471. [Google Scholar] [CrossRef]
- Evans, U.; Taylor, C. Mechanism of atmospheric rusting. Corros. Sci. 1972, 12, 227–246. [Google Scholar] [CrossRef]
- Crowyn, J. The Elements of Archaeological Conservation; Routledge: Eastbourne, UK, 1990. [Google Scholar]
- Thickett, D.; Odlyha, M. The formation and transformation of akaganeite. In Proceedings of the Interim Meeting of the International Council of Museums Committee for Conservation Metal Working Group, Edinburgh, Scotland, 16–20 September 2013; pp. 103–109. [Google Scholar]
- Oudbashi, O.; Shekofteh, A.; Makhzani, S.; Siapoosh, M. Conservation of metal collection in Ebn-E Sina Museum, Hamedan, Iran: From intervening to preventive approaches. In Proceedings of the YOCOCU 2014: Professionals’ Experiences in Cultural Heritage Conservation in America, Europe, and Asia: Proceedings of International Conference, Youth in the Conservation of Cultural Heritage, Agsu, Azerbaijan, 28–30 May 2014. [Google Scholar]
- Su, C.; Zhang, M.; Lin, L.; Yu, G.; Zhong, H.; Chong, Y. Reduction of iron oxides and microbial community composition in iron-rich soils with different organic carbon as electron donors. Int. Biodeterior. Biodegrad. 2020, 148, 104881. [Google Scholar] [CrossRef]
- Atlas, R. Handbook of Microbiological Media, 4th ed.; CRC Press: Boca Raton, FL, USA, 2010. [Google Scholar]
- Esther, J.; Sukla, L.B.; Pradhan, N.; Panda, S. Fe (III) reduction strategies of dissimilatory iron reducing bacteria. Korean J. Chem. Eng. 2015, 32, 1–14. [Google Scholar] [CrossRef]
- Brutinel, E.D.; Gralnick, J.A. Shuttling happens: Soluble flavin mediators of extracellular electron transfer in Shewanella. Appl. Microbiol. Biotechnol. 2011, 93, 41–48. [Google Scholar] [CrossRef]
- Zachara, D.; Kukkadapu, R.; Fredrickson, J.; Gorby, Y.; Smith, S. Biomineralisation of a poorly crystalline Fe (III) oxide, ak-aganeite, by an anaerobic Fe (III)-reducing bacterium (Shewanella alga) isolated from marine environment. Geomicrobiol. J. 2003, 7, 217. [Google Scholar]
- Konhauser, K. Diversity of bacterial iron mineralization. Earth-Sci. Rev. 1998, 43, 91–121. [Google Scholar] [CrossRef]
- Amezaga, J.M.; Amtmann, A.; Biggs, C.A.; Bond, T.; Gandy, C.J.; Honsbein, A.; Karunakaran, E.; Lawton, L.; Madsen, M.A.; Minas, K.; et al. Biodesalination: A case study for applications of photosynthetic bacteria in water treatment. Plant Physiol. 2014, 164, 1661–1676. [Google Scholar] [CrossRef] [Green Version]
- Cao, X.; Huang, X.; Liang, P.; Xiao, K.; Zhou, Y.; Zhang, X.; Logan, B.E. A new method for water desalination using microbial desalination cells. Environ. Sci. Technol. 2009, 43, 7148–7152. [Google Scholar] [CrossRef]
- Ramírez-Moreno, M.; Rodenas, P.; Aliaguilla, M.; Bosch-Jimenez, P.; Borràs, E.; Zamora, P.; Monsalvo, V.; Rogalla, F.; Ortiz, J.M.; Esteve-Núñez, A. Comparative performance of microbial desalination cells using air diffusion and liquid cathode reactions: Study of the salt removal and desalination efficiency. Front. Energy Res. 2019, 7, 1–12. [Google Scholar] [CrossRef] [Green Version]
- Pedireddy, S.; Jimenez-Sandoval, R.; Ravva, M.K.; Nayak, C.; Anjum, D.H.; Jha, S.N.; Katuri, K.P.; Saikaly, P.E. Harnessing the extracellular electron transfer capability of Geobacter sulfurreducens for ambient synthesis of stable bifunctional single-atom electrocatalyst for water splitting. Adv. Funct. Mater. 2021, 2010916. [Google Scholar] [CrossRef]
- Preston, J.; Smith, A.D.; Schofield, E.J.; Chadwick, A.; Jones, M.A.; Watts, J.E.M. The effects of Mary Rose conservation treatment on iron oxidation processes and microbial communities contributing to acid production in marine archaeological timbers. PLoS ONE 2014, 9, e84169. [Google Scholar] [CrossRef] [Green Version]
- Comensoli, L.; Kooli, W.; Monachon, M.; Albini, M.; Junier, P.; Joseph, E. The potential of microorganisms for the conserva-tion-restoration of iron artworks. In Proceedings of the Metal 2019 Interim Meeting of the ICOM-CC Metals Working Group; Chemello, C., Brambilla, L., Joseph, E., Eds.; International Council of Museums Committee for Conservation (ICOM-CC) and Haute Ecole Arc Conservation-Restauration (HE-Arc CR): Neuchatel, Switzerland, 2019; pp. 242–249. ISBN 978-92-9012-458-0. [Google Scholar]
- Comensoli, L. Interaction between Microbes, Iron and Chlorine for the Development of Biotechnological Approaches to Stabilise Corroded Iron. Ph.D. Thesis, University of Neuchatel, Neuchatel, Switzerland, 2017. [Google Scholar]
- Comensoli, L.; Albini, M.; Kooli, W.; Maillard, J.; Lombardo, T.; Junier, P.; Joseph, E. Investigation of biogenic passivating layers on corroded iron. Materials 2020, 13, 1176. [Google Scholar] [CrossRef] [PubMed] [Green Version]
- Kooli, W.M.; Comensoli, L.; Maillard, J.; Albini, M.; Gelb, A.; Junier, P.; Joseph, E. Bacterial iron reduction and biogenic mineral formation for the stabilisation of corroded iron objects. Sci. Rep. 2018, 8, 1–11. [Google Scholar] [CrossRef] [PubMed]
- Kooli, W.M.; Junier, T.; Shakya, M.; Monachon, M.; Davenport, K.W.; Vaideeswaran, K.; Vernudachi, A.; Marozau, I.; Monrouzeau, T.; Gleasner, C.D.; et al. Remedial treatment of corroded iron objects by environmental Aeromonas isolates. Appl. Environ. Microbiol. 2018, 85, e02042-18. [Google Scholar] [CrossRef] [Green Version]
- Benaiges-Fernandez, R.; Palau, J.; Offeddu, F.G.; Cama, J.; Urmeneta, J.; Soler, J.M.; Dold, B. Dissimilatory bioreduction of iron (III) oxides by Shewanella loihica under marine sediment conditions. Mar. Environ. Res. 2019, 151, 104782. [Google Scholar] [CrossRef]
- Kooli, W. Bacterial Iron Reduction and Biogenic Mineral Formation for the Stabilisation of Corroded Iron Objects. Ph.D. Thesis, University of Neuchatel, Neuchatel, Switzerland, 2018. [Google Scholar]
- Comensoli, L.; Maillard, J.; Albini, M.; Sandoz, F.; Junier, P.; Joseph, E. Use of bacteria to stabilize archaeological iron. Appl. Environ. Microbiol. 2017, 83. [Google Scholar] [CrossRef] [Green Version]
- Roh, Y.; Gao, V.H.; Vali, H.; Kennedy, D.W.; Yang, Z.K.; Gao, W.; Dohnalkova, A.C.; Stapleton, R.D.; Moon, J.-W.; Phelps, T.J.; et al. Metal reduction and iron biomineralization by a psychrotolerant Fe(III)-reducing bacterium, Shewanella sp. strain PV-4. Appl. Environ. Microbiol. 2006, 3236–3244. [Google Scholar] [CrossRef] [Green Version]
- Volkland, H.; Harms, H.; Wanner, O.; Zehnder, A. Corrosion protection by anaerobiosis. Water Sci. Technol. 2001, 44, 103–106. [Google Scholar] [CrossRef]
- Joseph, E.; James, S.; Albelda-Berenguer, M.; Albini, M.; Comensoli, L.; Cornet, E.; Beuret, E.; Kooli, W.; Brambilla, L.; Mathys, L.; et al. Groundbreaking approaches to green and sustainable metals conservation. In ICOM-CC 19th Triennial Conference 2021 Beijing Preprints; International Council of Museums: Paris, France, 2020. [Google Scholar]
- Suma, M.; Basheer, R.; Sreelekshmy, B.; Vipinlal, V.; Sha, M.A.; Jineesh, P.; Krishnan, A.; Archana, S.; Saji, V.S.; Shibli, S. Pseudomonas putida RSS biopassivation of mild steel for long term corrosion inhibition. Int. Biodeterior. Biodegrad. 2019, 137, 59–67. [Google Scholar] [CrossRef]
- Suma, M.S.; Basheer, R.; Sreelekshmy, B.R.; Riyas, A.H.; Bhagya, T.C.; Sha, M.A.; Shibli, S.M.A. Synergistic action of Bacillus subtilis, Escherichia coli and Shewanella putrefaciens along with Pseudomonas putida on inhibiting mild steel against oxygen corrosion. Appl. Microbiol. Biotechnol. 2019, 103, 5891–5905. [Google Scholar] [CrossRef] [PubMed]
- Frey, J. Part 1: Bacteria in Classification of Organisms; Institut für Veterinärbakteriologie, University Bern: Bern, Switzerland, 2010. [Google Scholar]
- Schwertmann, U.; Cornell, R. The Iron Oxides in the Laboratory: Preparation and Characterization, 2nd ed.; Wiley-VCH: Weinheim, Germany, 2000. [Google Scholar]
- Volkland, H.-P.; Harms, H.; Müller, B.; Repphun, G.; Wanner, O.; Zehnder, A.J.B. Bacterial phosphating of mild (unalloyed) steel. Appl. Environ. Microbiol. 2000, 66, 4389–4395. [Google Scholar] [CrossRef] [Green Version]
- Jia, Z.; Liu, Y.; Hwang, C.-A.; Huang, L. Effect of combination of Oxyrase and sodium thioglycolate on growth of Clostridium perfringens from spores under aerobic incubation. Food Microbiol. 2020, 89, 103413. [Google Scholar] [CrossRef] [PubMed]
- Souza, R.; Peruch, G.; Pires, A.C.D.S. Oxygen scavengers: An approach on food preservation. In Structure and Function of Food Engineering; IntechOpen: London, UK, 2012. [Google Scholar]
- Patel, J.R.; Hwang, C.-A.; Beuchat, L.R.; Doyle, M.P.; Brackett, R.E. Comparison of oxygen scavengers for their ability to enhance resuscitation of heat-injured Listeria monocytogenes. J. Food Prot. 1995, 58, 244–250. [Google Scholar] [CrossRef] [PubMed]
- Niroomand, F.; Fung, D.Y. Effect of oxyrase on growth of Salmonella spp. and Listeria monocytogenes in the “universal preenrichment medium”. J. Rapid Methods Autom. Microbiol. 1992, 1, 241–247. [Google Scholar] [CrossRef]
- Liu, S.; Ellars, C.; Edwards, D. Ascorbic acid: Useful as a buffer agent and radiolytic stabilizer for metalloradiopharmaceu-ticals. Bioconj. Chem. 2003, 14, 1052–10526. [Google Scholar] [CrossRef] [PubMed]
- National Toxicology Program, U.S. Department of Health and Human Services. Testing Status of Sodium Thioglycolate 10613-K. Available online: https://ntp.niehs.nih.gov/whatwestudy/testpgm/status/ts-10613-k.html?utm_source=direct&utm_medium=prod&utm_campaign=ntpgolinks&utm_term=ts-10613-k (accessed on 4 August 2020).

| NB Variations | LB Variations | ||||||||||||||
|---|---|---|---|---|---|---|---|---|---|---|---|---|---|---|---|
| Label | Soytone (g/L) | Yeast (g/L) | Glucose (g/L) | Sodium Source (g/L) | Label | Soytone (g/L) | Yeast (g/L) | Glucose (g/L) | Sodium Source (g/L) | ||||||
| NBa (NB) | 15 | 5 | 1 | 10 | NaCl | -- | -- | LBa (LB) | 10 | 5 | -- | 10 | NaCl | -- | -- |
| NBb (NBS) | 15 | 5 | 1 | -- | -- | -- | -- | LBa (LBS) | 10 | 5 | -- | -- | -- | -- | -- |
| NBc | 15 | 5 | 1 | 10 | NaCl | 0.865 | Sodium Benzoate | LBc | 10 | 5 | -- | 10 | NaCl | 0.865 | Sodium Benzoate |
| NBd | 15 | 5 | 1 | -- | -- | 0.865 | Sodium Benzoate | LBd | 10 | 5 | -- | -- | -- | 0.865 | Sodium Benzoate |
| NBe | 15 | 5 | 1 | 10 | Na2SO4 | -- | -- | LBe | 10 | 5 | -- | 10 | Na2SO4 | -- | -- |
| NBf | 15 | 5 | 1 | 5 | NaCl | -- | -- | LBf | 10 | 5 | -- | 5 | NaCl | -- | -- |
| Solution | Concentration | |||
|---|---|---|---|---|
| 1 | 2 | 3 | ||
| Vitamin C (Vit) | mg/L | 100 | 250 | 500 |
| Sodium Thioglycolate (Thio) | mg/L | 250 | 500 | 1000 |
| Oxyrase for Broth (OXR) | mL/L | 0.625 | 1.250 | 1.875 |
| No Addition (Norm) | -- | |||
| Solution | Iron Content (mg/L) | Chloride Content (mg/L) | |
|---|---|---|---|
| VSP | ICP | VSP | |
| LBa (LB) | 1.01 ± 0.24 | 1.02 | 6403.33 ± 125.03 |
| LBb (LBS) | 1.31 ± 0.34 | 2.06 | 153.67 ± 1.15 |
| NBa (NB) | 1.48 ± 0.02 | 1.03 | 6176.67 ± 51.32 |
| NBb (NBS) | 2.85 ± 0.13 | -- | 52.30 ± 10.4 |
Publisher’s Note: MDPI stays neutral with regard to jurisdictional claims in published maps and institutional affiliations. |
© 2021 by the authors. Licensee MDPI, Basel, Switzerland. This article is an open access article distributed under the terms and conditions of the Creative Commons Attribution (CC BY) license (https://creativecommons.org/licenses/by/4.0/).
Share and Cite
James, S.; Joseph, E. Microbial-Driven Stabilisation of Archaeological Iron Artefacts. Corros. Mater. Degrad. 2021, 2, 274-292. https://doi.org/10.3390/cmd2020015
James S, Joseph E. Microbial-Driven Stabilisation of Archaeological Iron Artefacts. Corrosion and Materials Degradation. 2021; 2(2):274-292. https://doi.org/10.3390/cmd2020015
Chicago/Turabian StyleJames, Sarah, and Edith Joseph. 2021. "Microbial-Driven Stabilisation of Archaeological Iron Artefacts" Corrosion and Materials Degradation 2, no. 2: 274-292. https://doi.org/10.3390/cmd2020015
APA StyleJames, S., & Joseph, E. (2021). Microbial-Driven Stabilisation of Archaeological Iron Artefacts. Corrosion and Materials Degradation, 2(2), 274-292. https://doi.org/10.3390/cmd2020015






